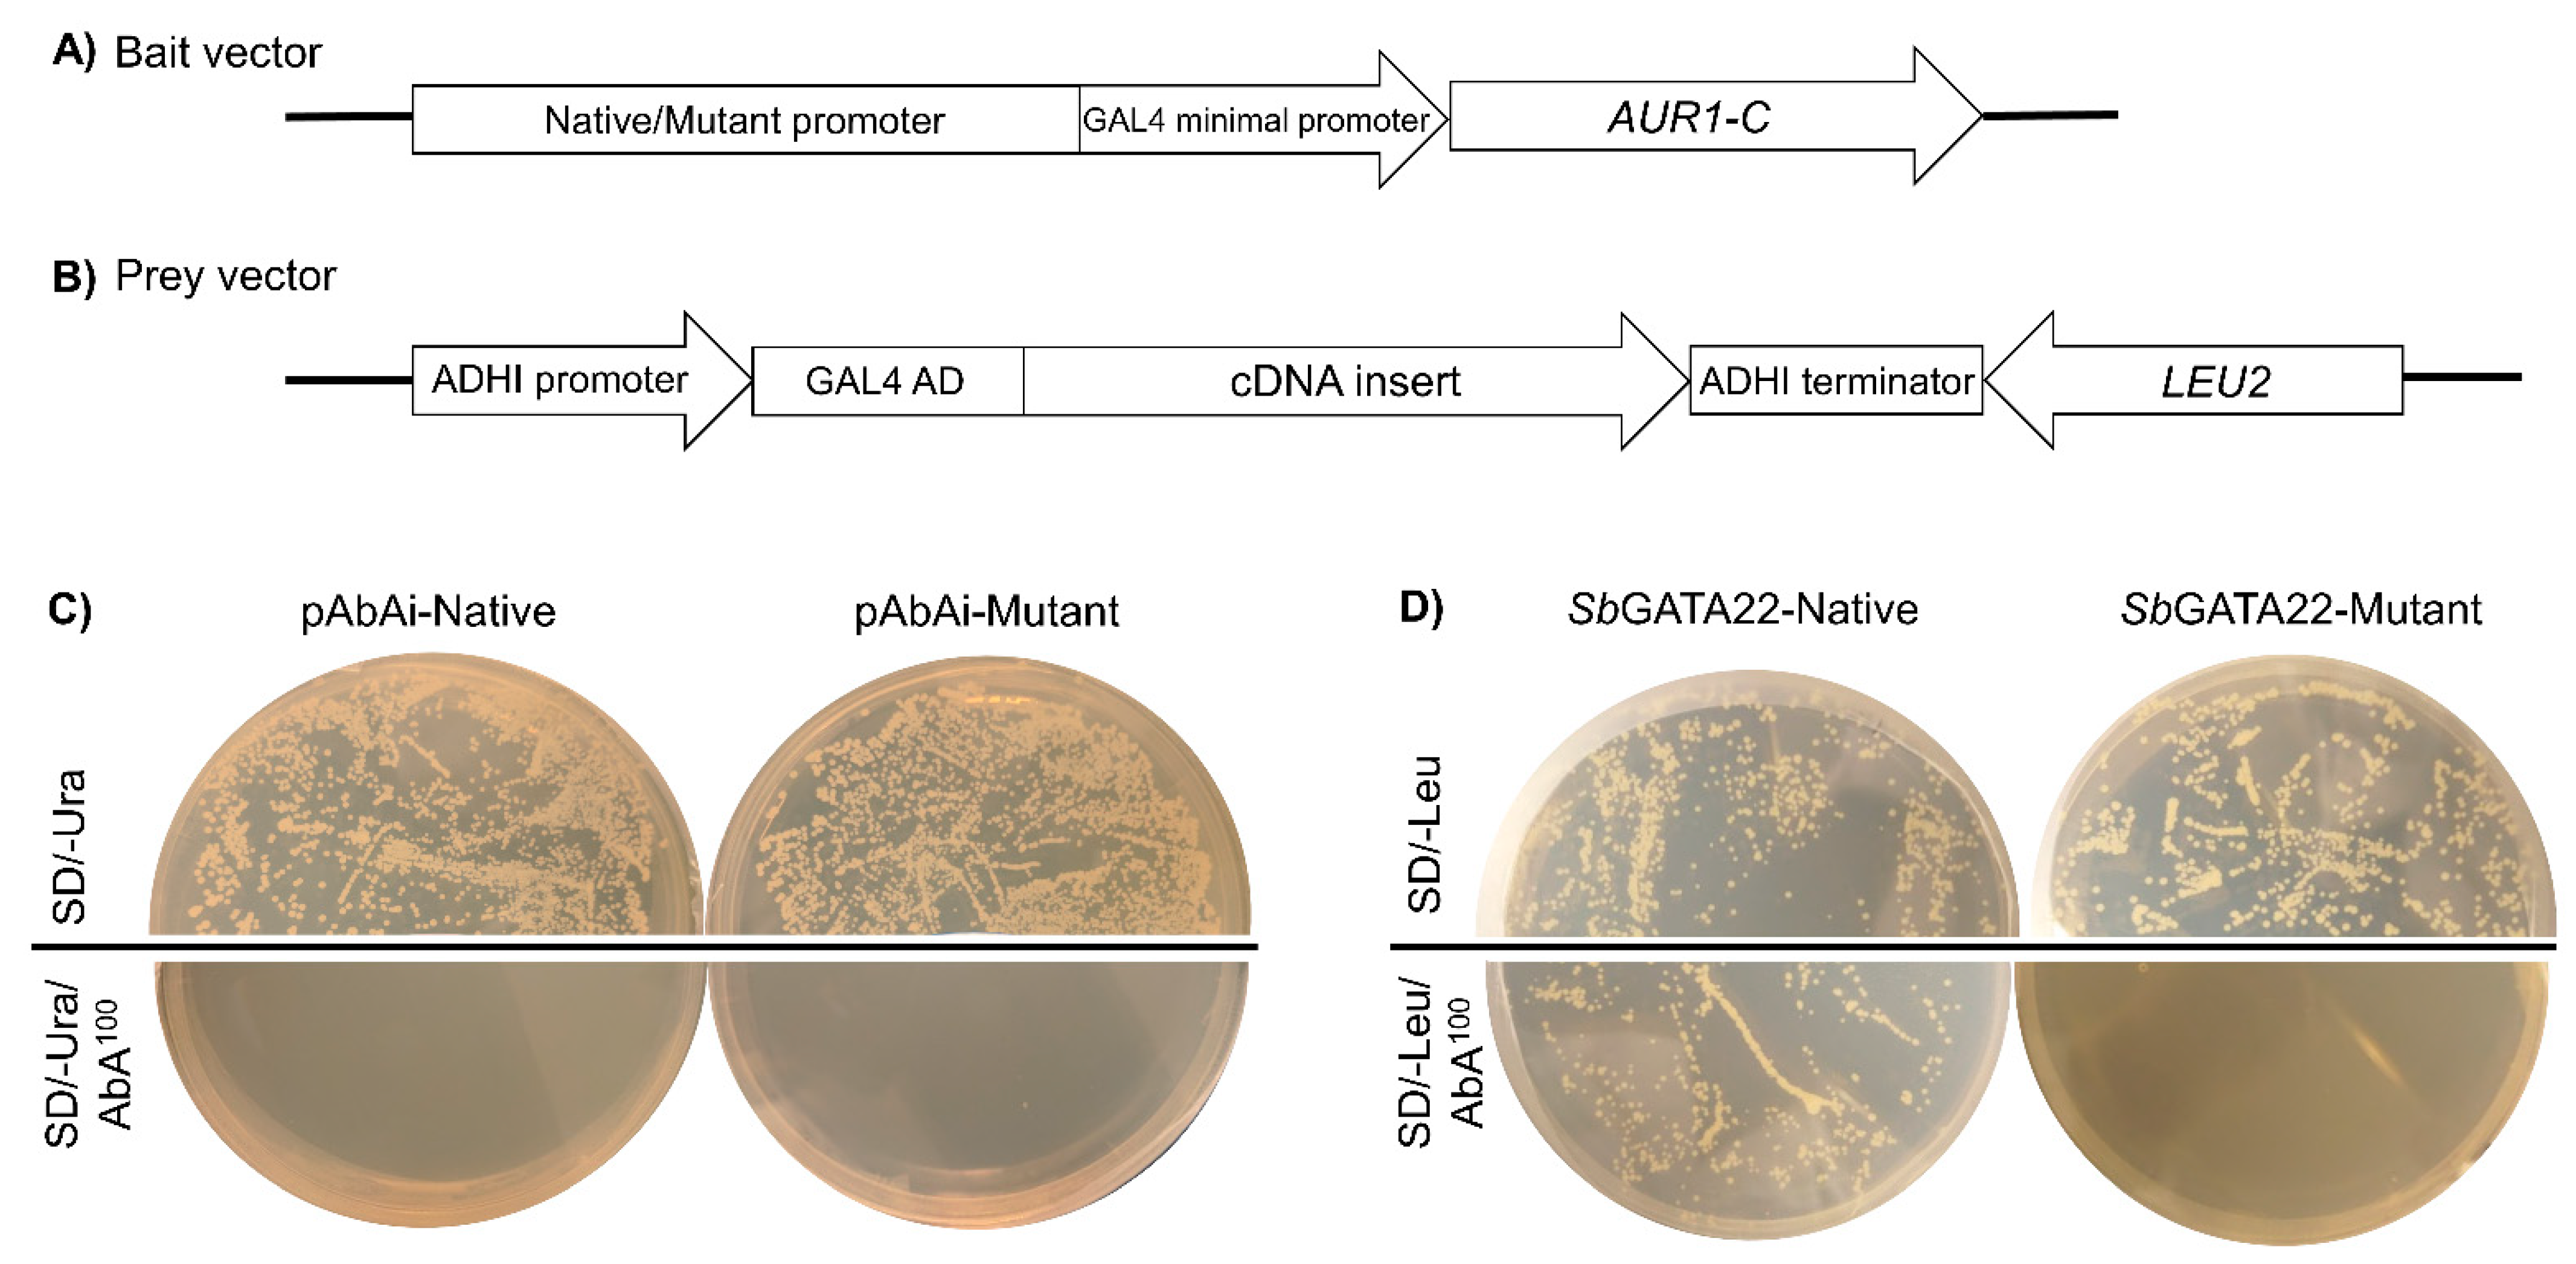

The Putative GATA Transcription Factor SbGATA22 as a Novel Regulator of Dhurrin Biosynthesis
Abstract
1. Introduction
2. Materials and Methods
2.1. Yeast One-Hybrid Screen: Construction of the CYP79A1 Promoter–AbAi Reporter (Bait) Plasmids
2.2. Plant Material
2.3. RNA Extraction and cDNA Library Construction
2.4. cDNA Synthesis for Library Construction
2.5. cDNA Library Screening
2.6. Expression of SbGATA22 during Development
2.7. Gene Expression in Response to Nitrogen Application
2.8. HCNp Analysis
2.9. Quantitative PCR (qPCR)
2.10. Sequencing and Bioinformatic Analysis
2.11. Subcellular Localization of Transiently Expressed SbGATA22
2.12. Statistics
3. Results
3.1. Identification of a Novel GATA Transcription Factor That Binds to the SbCYP79A1 Promoter
3.2. Confirmation of SbGATA22 Binding to GATA Transcription Factor Binding Motifs
3.3. Homology of SbGATA22
3.4. Subcellular Localization of SbGATA22
3.5. Developmental Expression of SbGATA22
3.6. Expression of SbGATA22 in Response to Nitrogen Application
4. Discussion
4.1. GATA Transcription Factors in Plant Development and Stress Responses
4.2. SbGATA22 Expression in Response to Nitrogen Application
5. Conclusions
Supplementary Materials
Author Contributions
Funding
Institutional Review Board Statement
Informed Consent Statement
Data Availability Statement
Acknowledgments
Conflicts of Interest
References
- Gleadow, R.M.; Møller, B.L. Cyanogenic Glycosides: Synthesis, physiology, and phenotypic plasticity. Annu. Rev. Plant Biol. 2014, 65, 155–185. [Google Scholar] [CrossRef] [PubMed]
- Jones, D.A. Why are so many food plants cyanogenic? Phytochemistry 1998, 47, 155–162. [Google Scholar] [CrossRef] [PubMed]
- Gleadow, R.; Woodrow, I. Constraints on the effectiveness of cyanogenic glycosides in herbivore defence [mini review]. J. Chem. Ecol. 2002, 28, 1301–1313. [Google Scholar] [CrossRef] [PubMed]
- Holland, M.A.; Kozlowski, L.M. Clinical features and management of cyanide poisoning. Clin. Pharm. 1986, 5, 737–741. [Google Scholar] [PubMed]
- Jenrich, R.; Trompetter, I.; Bak, S.; Olsen, C.E.; Møller, B.L.; Piotrowski, M. Evolution of heteromeric nitrilase complexes in Poaceae with new functions in nitrile metabolism. Proc. Natl. Acad. Sci. USA 2007, 104, 18848–18853. [Google Scholar] [CrossRef] [PubMed]
- Pičmanová, M.; Neilson, E.H.; Motawia, M.S.; Olsen, C.E.; Agerbirk, N.; Gray, C.J.; Flitsch, S.; Meier, S.; Silvestro, D.; Jørgensen, K.; et al. A recycling pathway for cyanogenic glycosides evidenced by the comparative metabolic profiling in three cyanogenic plant species. Biochem. J. 2015, 469, 375–389. [Google Scholar] [CrossRef] [PubMed]
- Bjarnholt, N.; Neilson, E.H.J.; Crocoll, C.; Jørgensen, K.; Motawia, M.S.; Olsen, C.E.; Dixon, D.P.; Edwards, R.; Møller, B.L. Glutathione transferases catalyze recycling of auto-toxic cyanogenic glucosides in sorghum. Plant J. 2018, 94, 1109–1125. [Google Scholar] [CrossRef] [PubMed]
- Gleadow, R.M.; McKinley, B.A.; Blomstedt, C.K.; Lamb, A.C.; Møller, B.L.; Mullet, J.E. Regulation of dhurrin pathway gene expression during Sorghum bicolor development. Planta 2021, 254, 119. [Google Scholar] [CrossRef] [PubMed]
- Zagrobelny, M.; Bak, S.; Rasmussen, A.V.; Jorgensen, B.; Naumann, C.M.; Møller, B.L. Cyanogenic glucosides and plant-insect interactions. Phytochemistry 2004, 65, 293–306. [Google Scholar] [CrossRef] [PubMed]
- Ballhorn, D.J.; Pietrowski, A.; Lieberei, R. Direct trade-off between cyanogenesis and resistance to a fungal pathogen in lima bean (Phaseolus lunatus L.). J. Ecol. 2010, 98, 226–236. [Google Scholar] [CrossRef]
- Emendack, Y.; Burke, J.; Laza, H.; Sanchez, J.; Hayes, C. Abiotic stress effects on sorghum leaf dhurrin and soluble sugar contents throughout plant development. Crop Sci. 2018, 58, 1706–1716. [Google Scholar] [CrossRef]
- Blomstedt, C.K.; Rosati, V.C.; Lindberg Møller, B.; Gleadow, R. Counting the costs: Nitrogen partitioning in sorghum mutants. Funct. Plant Biol. 2018, 45, 705–718. [Google Scholar] [CrossRef] [PubMed]
- Wheeler, J.; Mulcahy, C. Consequences for animal production of cyanogenesis in sorghum forage and hay—A review. Trop. Grassl. 1989, 23, 193–202. [Google Scholar]
- Gleadow, R.M.; Ottman, M.J.; Kimball, B.A.; Wall, G.W.; Pinter, P.J.; LaMorte, R.L.; Leavitt, S.W. Drought–induced changes in nitrogen partitioning in sorghum are not moderated by elevated CO2 in FACE studies. Field Crops Res. 2016, 185, 97–102. [Google Scholar] [CrossRef]
- Jørgensen, K.; Bak, S.; Busk, P.K.; Sørensen, C.; Olsen, C.E.; Puonti-Kaerlas, J.; Møller, B.L. Cassava plants with a depleted cyanogenic glucoside content in leaves and tubers. distribution of cyanogenic glucosides, their site of synthesis and transport, and blockage of the biosynthesis by RNA interference technology. Plant Physiol. 2005, 139, 363–374. [Google Scholar] [CrossRef] [PubMed]
- Gruss, S.M.; Ghaste, M.; Widhalm, J.R.; Tuinstra, M.R. Seedling growth and fall armyworm feeding preference influenced by dhurrin production in sorghum. Theor. Appl. Genet. 2022, 135, 1037–1047. [Google Scholar] [CrossRef] [PubMed]
- Sohail, M.N.; Blomstedt, C.K.; Gleadow, R.M. Allocation of resources to cyanogenic glucosides does not incur a growth sacrifice in Sorghum bicolor (L.) Moench. Plants 2020, 9, 1791. [Google Scholar] [CrossRef] [PubMed]
- Nielsen, L.J.; Stuart, P.; Pičmanová, M.; Rasmussen, S.; Olsen, C.E.; Harholt, J.; Møller, B.L.; Bjarnholt, N. Dhurrin metabolism in the developing grain of Sorghum bicolor (L.) Moench investigated by metabolite profiling and novel clustering analyses of time-resolved transcriptomic data. BMC Genom. 2016, 17, 1021. [Google Scholar] [CrossRef] [PubMed]
- Halkier, B.A.; Møller, B.L. Biosynthesis of the cyanogenic glucoside dhurrin in seedlings of Sorghum bicolor (L.) Moench and partial purification of the enzyme system involved. Plant Physiol. 1989, 90, 1552–1559. [Google Scholar] [CrossRef] [PubMed]
- Busk, P.K.; Møller, B.L. Dhurrin synthesis in sorghum is regulated at the transcriptional level and induced by nitrogen fertilization in older plants. Plant Physiol. 2002, 129, 1222–1231. [Google Scholar] [CrossRef] [PubMed]
- Sibbesen, O.; Koch, B.; Halkier, B.A.; Møller, B.L. Cytochrome P-450[IMAGE] Is a multifunctional heme-thiolate enzyme catalyzing the conversion of L-Tyrosine to p-Hydroxyphenylacetaldehyde oxime in the biosynthesis of the cyanogenic glucoside dhurrin in Sorghum bicolor (L.) Moench. J. Biol. Chem. 1995, 270, 3506–3511. [Google Scholar] [CrossRef] [PubMed]
- Koch, B.M.; Sibbesen, O.; Halkier, B.A.; Svendsen, I.; Møller, B.L. The primary sequence of cytochrome P450tyr, the multifunctional N-Hydroxylase catalyzing the conversion of L-Tyrosine to p-Hydroxyphenylacetaldehyde oxime in the biosynthesis of the cyanogenic glucoside dhurrin in Sorghum bicolor (L.) Moench. Arch. Biochem. Biophys. 1995, 323, 177–186. [Google Scholar] [CrossRef] [PubMed]
- Bak, S.; Kahn, R.A.; Nielsen, H.L.; Møller, B.L.; Halkier, B.A. Cloning of three A-type cytochromes P450, CYP71E1, CYP98, and CYP99 from Sorghum bicolor (L.) Moench by a PCR approach and identification by expression in Escherichia coli of CYP71E1 as a multifunctional cytochrome P450 in the biosynthesis of the cyanogenic glucoside dhurrin. Plant Mol. Biol. 1998, 36, 393–405. [Google Scholar]
- Takos, A.M.; Knudsen, C.; Lai, D.; Kannangara, R.; Mikkelsen, L.; Motawia, M.S.; Olsen, C.E.; Sato, S.; Tabata, S.; Jørgensen, K.; et al. Genomic clustering of cyanogenic glucoside biosynthetic genes aids their identification in Lotus japonicus and suggests the repeated evolution of this chemical defence pathway. Plant J. 2011, 68, 273–286. [Google Scholar] [CrossRef]
- Rosati, V.; Quinn, A.; Fromhold, S.; Gleadow, R.; Blomstedt, C. Investigation into the role of DNA methylation in cyanogenesis in sorghum (Sorghum bicolor L. Moench). Plant Growth Regul. 2019, 88, 73–85. [Google Scholar] [CrossRef]
- Buchanan, C.D.; Lim, S.; Salzman, R.A.; Kagiampakis, I.; Morishige, D.T.; Weers, B.D.; Klein, R.R.; Pratt, L.H.; Cordonnier-Pratt, M.-M.; Klein, P.E.; et al. Sorghum bicolor’s transcriptome response to dehydration, high salinity and ABA. Plant Mol. Biol. 2005, 58, 699–720. [Google Scholar] [CrossRef] [PubMed]
- Katamreddy, S.C.; Reddy, B.P.; Kishor, P.B.K.; Kumar, A.A.; Reddy, P.S. Identification and expression profile of dhurrin biosynthesis pathway genes in sorghum vegetative tissues. Plant Biotechnol. Rep. 2024. [Google Scholar] [CrossRef]
- Sohail, M.N.; O’Donnell, N.H.; Kaiser, B.N.; Blomstedt, C.K.; Gleadow, R.M. Wounding and methyl jasmonate increase cyanogenic glucoside concentrations in Sorghum bicolor via upregulation of biosynthesis. Plant Biol. 2023, 25, 498–508. [Google Scholar] [CrossRef] [PubMed]
- Blomstedt, C.K.; Gleadow, R.M.; O’Donnell, N.; Naur, P.; Jensen, K.; Laursen, T.; Olsen, C.E.; Stuart, P.; Hamill, J.D.; Møller, B.L.; et al. A combined biochemical screen and TILLING approach identifies mutations in Sorghum bicolor L. Moench resulting in acyanogenic forage production. Plant Biotechnol. J. 2012, 10, 54–66. [Google Scholar] [CrossRef] [PubMed]
- Blomstedt, C.K.; O’Donnell, N.H.; Bjarnholt, N.; Neale, A.D.; Hamill, J.D.; Møller, B.L.; Gleadow, R.M. Metabolic consequences of knocking out UGT85B1, the gene encoding the glucosyltransferase required for synthesis of dhurrin in Sorghum bicolor (L. Moench). Plant Cell Physiol. 2016, 57, 373–386. [Google Scholar] [CrossRef]
- Sánchez-Pérez, R.; Pavan, S.; Mazzeo, R.; Moldovan, C.; Cigliano, R.A.; Del Cueto, J.; Ricciardi, F.; Lotti, C.; Ricciardi, L.; Dicenta, F.; et al. Mutation of a bHLH transcription factor allowed almond domestication. Science 2019, 364, 1095–1098. [Google Scholar] [CrossRef] [PubMed]
- Chen, C.; Liu, F.; Zhang, K.; Niu, X.; Zhao, H.; Liu, Q.; Georgiev, M.I.; Xu, X.; Zhang, X.; Zhou, M. MeJA-responsive bHLH transcription factor LjbHLH7 regulates cyanogenic glucoside biosynthesis in Lotus japonicus. J. Exp. Bot. 2022, 73, 2650–2665. [Google Scholar] [CrossRef] [PubMed]
- Ouwerkerk, P.B.; Meijer, A.H. Yeast one-hybrid screening for DNA-protein interactions. Curr. Protoc. Mol. Biol. 2001, 55, 11–12. [Google Scholar] [CrossRef] [PubMed]
- Reece-Hoyes, J.S.; Marian Walhout, A.J. Yeast one-hybrid assays: A historical and technical perspective. Methods 2012, 57, 441–447. [Google Scholar] [CrossRef] [PubMed]
- Tang, M.; Li, B.; Zhou, X.; Bolt, T.; Li, J.J.; Cruz, N.; Gaudinier, A.; Ngo, R.; Clark-Wiest, C.; Kliebenstein, D.J.; et al. A genome-scale TF-DNA interaction network of transcriptional regulation of Arabidopsis primary and specialized metabolism. Mol. Syst. Biol. 2021, 17, e10625. [Google Scholar] [CrossRef] [PubMed]
- Yang, F.; Li, W.; Jiang, N.; Yu, H.; Morohashi, K.; Ouma, W.Z.; Morales-Mantilla, D.E.; Gomez-Cano, F.A.; Mukundi, E.; Prada-Salcedo, L.D.; et al. A maize gene regulatory network for phenolic metabolism. Mol. Plant 2017, 10, 498–515. [Google Scholar] [CrossRef]
- Verwoerd, T.C.; Dekker, B.M.M.; Hoekema, A. A small-scale procedure for the rapid isolation of plant RNAs. Nucleic Acid Res. 1989, 17, 2362. [Google Scholar] [CrossRef] [PubMed]
- Gleadow, R.; Bjarnholt, N.; Jørgensen, K.; Fox, J.; Miller, R. Detection, identification and quantitative measurement of cyanogenic glycosides. In Research Methods in Plant Science: Soil Allelochemicals; Narwal, S.S., Szajdak, L., Sampietro, D.A., Eds.; International Allelopathy Foundation, Studium Press: Houston, TX, USA, 2012; Volume 1, pp. 283–310, Chapter 12. [Google Scholar]
- Simon, P. Q-Gene: Processing quantitative real-time RT–PCR data. Bioinformatics 2003, 19, 1439–1440. [Google Scholar] [CrossRef] [PubMed]
- Edgar, R.C. MUSCLE: Multiple sequence alignment with high accuracy and high throughput. Nucleic Acids Res. 2004, 32, 1792–1797. [Google Scholar] [CrossRef] [PubMed]
- Waterhouse, A.M.; Procter, J.B.; Martin, D.M.; Clamp, M.; Barton, G.J. Jalview Version 2—A multiple sequence alignment editor and analysis workbench. Bioinformatics 2009, 25, 1189–1191. [Google Scholar] [CrossRef] [PubMed]
- Chow, C.-N.; Zheng, H.-Q.; Wu, N.-Y.; Chien, C.-H.; Huang, H.-D.; Lee, T.-Y.; Chiang-Hsieh, Y.-F.; Hou, P.-F.; Yang, T.-Y.; Chang, W.-C. PlantPAN 2.0: An update of plant promoter analysis navigator for reconstructing transcriptional regulatory networks in plants. Nucleic Acids Res. 2015, 44, D1154–D1160. [Google Scholar] [CrossRef] [PubMed]
- Jin, J.; Tian, F.; Yang, D.-C.; Meng, Y.-Q.; Kong, L.; Luo, J.; Gao, G. PlantTFDB 4.0: Toward a central hub for transcription factors and regulatory interactions in plants. Nucleic Acids Res. 2017, 45, D1040–D1045. [Google Scholar] [CrossRef] [PubMed]
- Gasteiger, E.; Hoogland, C.; Gattiker, A.; Duvaud, S.e.; Wilkins, M.R.; Appel, R.D.; Bairoch, A. Protein Identification and Analysis Tools on the ExPASy Server. In The Proteomics Protocols Handbook; Walker, J.M., Ed.; Humana Press: Totowa, NJ, USA, 2005; pp. 571–607. [Google Scholar]
- Sambrook, J.; Fritsch, E.F.; Maniatus, T. Molecular Cloning: A Laboratory Manual, 2nd ed.; Cold Spring Harbor Laboratory: Cold Spring Harbor, NY, USA, 1989. [Google Scholar]
- Karimi, M.; Depicker, A.; Hilson, P. Recombinational cloning with plant gateway vectors. Plant Physiol. 2007, 145, 1144–1154. [Google Scholar] [CrossRef] [PubMed]
- Wydro, M.; Kozubek, E.; Lehmann, P. Optimization of transient Agrobacterium-mediated gene expression system in leaves of Nicotiana benthamiana. Acta Biochim. Pol. 2006, 53, 289. [Google Scholar] [CrossRef]
- Yao, X.; Lai, D.; Zhou, M.; Ruan, J.; Ma, C.; Wu, W.; Weng, W.; Fan, Y.; Cheng, J. Genome-wide identification, evolution and expression pattern analysis of the GATA gene family in Sorghum bicolor. Front. Plant Sci. 2023, 14, 1163357. [Google Scholar] [CrossRef] [PubMed]
- Ranftl, Q.L.; Bastakis, E.; Klermund, C.; Schwechheimer, C. LLM-domain containing B-GATA factors control different aspects of cytokinin-regulated development in Arabidopsis thaliana. Plant Physiol. 2016, 170, 2295–2311. [Google Scholar] [CrossRef] [PubMed]
- Behringer, C.; Bastakis, E.; Ranftl, Q.L.; Mayer, K.F.; Schwechheimer, C. Functional diversification within the family of B-GATA transcription factors through the leucine-leucine-methionine domain. Plant Physiol. 2014, 166, 293–305. [Google Scholar] [CrossRef] [PubMed]
- Weirauch, M.T.; Yang, A.; Albu, M.; Cote, A.G.; Montenegro-Montero, A.; Drewe, P.; Najafabadi, H.S.; Lambert, S.A.; Mann, I.; Cook, K. Determination and inference of eukaryotic transcription factor sequence specificity. Cell 2014, 158, 1431–1443. [Google Scholar] [CrossRef] [PubMed]
- Behringer, C.; Schwechheimer, C. B-GATA transcription factors–insights into their structure, regulation, and role in plant development. Front. Plant Sci. 2015, 6, 90. [Google Scholar] [CrossRef] [PubMed]
- Schwechheimer, C.; Schröder, P.M.; Blaby-Haas, C.E. Plant GATA factors: Their biology, phylogeny, and phylogenomics. Annu. Rev. Plant Biol. 2022, 73, 123–148. [Google Scholar] [CrossRef] [PubMed]
- Gao, S.; Gao, J.; Zhu, X.; Song, Y.; Li, Z.; Ren, G.; Zhou, X.; Kuai, B. ABF2, ABF3, and ABF4 promote ABA-mediated chlorophyll degradation and leaf senescence by transcriptional activation of chlorophyll catabolic genes and senescence-associated genes in Arabidopsis. Mol. Plant 2016, 9, 1272–1285. [Google Scholar] [CrossRef]
- Xu, Z.; Casaretto, J.A.; Bi, Y.M.; Rothstein, S.J. Genome-wide binding analysis of AtGNC and AtCGA1 demonstrates their cross-regulation and common and specific functions. Plant Direct 2017, 1, e00016. [Google Scholar] [CrossRef]
- Argüello-Astorga, G.; Herrera-Estrella, L. Evolution of light-regulated plant promoters. Annu. Rev. Plant Biol. 1998, 49, 525–555. [Google Scholar] [CrossRef] [PubMed]
- Chiang, Y.-H.; Zubo, Y.O.; Tapken, W.; Kim, H.J.; Lavanway, A.M.; Howard, L.; Pilon, M.; Kieber, J.J.; Schaller, G.E. Functional characterization of the GATA transcription factors GNC and CGA1 reveals their key role in chloroplast development, growth, and division in Arabidopsis. Plant Physiol. 2012, 160, 332–348. [Google Scholar] [CrossRef] [PubMed]
- Liu, Y.; Patra, B.; Pattanaik, S.; Wang, Y.; Yuan, L. GATA and phytochrome interacting factor transcription factors regulate light-induced vindoline biosynthesis in Catharanthus roseus. Plant Physiol 2019, 180, 1336–1350. [Google Scholar] [CrossRef] [PubMed]
- Hudson, D.; Guevara, D.; Yaish, M.W.; Hannam, C.; Long, N.; Clarke, J.D.; Bi, Y.-M.; Rothstein, S.J. GNC and CGA1 modulate chlorophyll biosynthesis and glutamate synthase (GLU1/Fd-GOGAT) expression in Arabidopsis. PLoS ONE 2011, 6, e26765. [Google Scholar] [CrossRef] [PubMed]
- Klermund, C.; Ranftl, Q.L.; Diener, J.; Bastakis, E.; Richter, R.; Schwechheimer, C. LLM-domain B-GATA transcription factors promote stomatal development downstream of light signaling pathways in Arabidopsis thaliana hypocotyls. Plant Cell 2016, 28, 646–660. [Google Scholar] [CrossRef] [PubMed]
- Reyes, J.C.; Muro-Pastor, M.I.; Florencio, F.J. The GATA family of transcription factors in Arabidopsis and rice. Plant Physiol. 2004, 134, 1718–1732. [Google Scholar] [CrossRef] [PubMed]
- Gupta, P.; Nutan, K.K.; Singla-Pareek, S.L.; Pareek, A. Abiotic stresses cause differential regulation of alternative splice forms of GATA transcription factor in rice. Front. Plant Sci. 2017, 8, 1944. [Google Scholar] [CrossRef] [PubMed]
- Feng, X.; Yu, Q.; Zeng, J.; He, X.; Liu, W. Genome-wide identification and characterization of GATA family genes in wheat. BMC Plant Biol. 2022, 22, 372. [Google Scholar] [CrossRef] [PubMed]
- Lai, D.; Yao, X.; Yan, J.; Gao, A.; Yang, H.; Xiang, D.; Ruan, J.; Fan, Y.; Cheng, J. Genome-wide identification, phylogenetic and expression pattern analysis of GATA family genes in foxtail millet (Setaria italica). BMC Genom. 2022, 23, 549. [Google Scholar] [CrossRef] [PubMed]
- Peng, W.; Li, W.; Song, N.; Tang, Z.; Liu, J.; Wang, Y.; Pan, S.; Dai, L.; Wang, B. Genome-wide characterization, evolution, and expression profile analysis of GATA transcription factors in Brachypodium distachyon. Int. J. Mol. Sci. 2021, 22, 2026. [Google Scholar] [CrossRef] [PubMed]
- O’Donnell, N.H.; Møller, B.L.; Neale, A.D.; Hamill, J.D.; Blomstedt, C.K.; Gleadow, R.M. Effects of PEG-induced osmotic stress on growth and dhurrin levels of forage sorghum. Plant Physiol. Biochem. 2013, 73, 83–92. [Google Scholar] [CrossRef] [PubMed]
- Hudson, D.; Guevara, D.R.; Hand, A.J.; Xu, Z.; Hao, L.; Chen, X.; Zhu, T.; Bi, Y.-M.; Rothstein, S.J. Rice cytokinin GATA transcription factor1 regulates chloroplast development and plant architecture. Plant Physiol. 2013, 162, 132–144. [Google Scholar] [CrossRef] [PubMed]
- Schmidt, F.B.; Cho, S.K.; Olsen, C.E.; Yang, S.W.; Møller, B.L.; Jørgensen, K. Diurnal regulation of cyanogenic glucoside biosynthesis and endogenous turnover in cassava. Plant Direct 2018, 2, e00038. [Google Scholar] [CrossRef] [PubMed]
- Fox, A.H.; Liew, C.; Holmes, M.; Kowalski, K.; Mackay, J.; Crossley, M. Transcriptional cofactors of the FOG family interact with GATA proteins by means of multiple zinc fingers. EMBO J. 1999, 18, 2812–2822. [Google Scholar] [CrossRef]
- Robert, N.M.; Tremblay, J.J.; Viger, R.S. Friend of GATA (FOG)-1 and FOG-2 differentially repress the GATA-dependent activity of multiple gonadal promoters. Endocrinology 2002, 143, 3963–3973. [Google Scholar] [CrossRef]
- Causier, B.; Ashworth, M.; Guo, W.; Davies, B. The TOPLESS interactome: A framework for gene repression in Arabidopsis. Plant Physiol. 2012, 158, 423–438. [Google Scholar] [CrossRef] [PubMed]
- Bowen, A.J.; Gonzalez, D.; Mullins, J.G.; Bhatt, A.M.; Martinez, A.; Conlan, R.S. PAH-domain-specific interactions of the Arabidopsis transcription coregulator SIN3-LIKE1 (SNL1) with telomere-binding protein 1 and ALWAYS EARLY2 Myb-DNA binding factors. J. Mol. Biol. 2010, 395, 937–949. [Google Scholar] [CrossRef] [PubMed]

Disclaimer/Publisher’s Note: The statements, opinions and data contained in all publications are solely those of the individual author(s) and contributor(s) and not of MDPI and/or the editor(s). MDPI and/or the editor(s) disclaim responsibility for any injury to people or property resulting from any ideas, methods, instructions or products referred to in the content. |
© 2024 by the authors. Licensee MDPI, Basel, Switzerland. This article is an open access article distributed under the terms and conditions of the Creative Commons Attribution (CC BY) license (https://creativecommons.org/licenses/by/4.0/).
Share and Cite
Rosati, V.C.; Quinn, A.A.; Gleadow, R.M.; Blomstedt, C.K. The Putative GATA Transcription Factor SbGATA22 as a Novel Regulator of Dhurrin Biosynthesis. Life 2024, 14, 470. https://doi.org/10.3390/life14040470
Rosati VC, Quinn AA, Gleadow RM, Blomstedt CK. The Putative GATA Transcription Factor SbGATA22 as a Novel Regulator of Dhurrin Biosynthesis. Life. 2024; 14(4):470. https://doi.org/10.3390/life14040470
Chicago/Turabian StyleRosati, Viviana C., Alicia A. Quinn, Roslyn M. Gleadow, and Cecilia K. Blomstedt. 2024. "The Putative GATA Transcription Factor SbGATA22 as a Novel Regulator of Dhurrin Biosynthesis" Life 14, no. 4: 470. https://doi.org/10.3390/life14040470
APA StyleRosati, V. C., Quinn, A. A., Gleadow, R. M., & Blomstedt, C. K. (2024). The Putative GATA Transcription Factor SbGATA22 as a Novel Regulator of Dhurrin Biosynthesis. Life, 14(4), 470. https://doi.org/10.3390/life14040470

